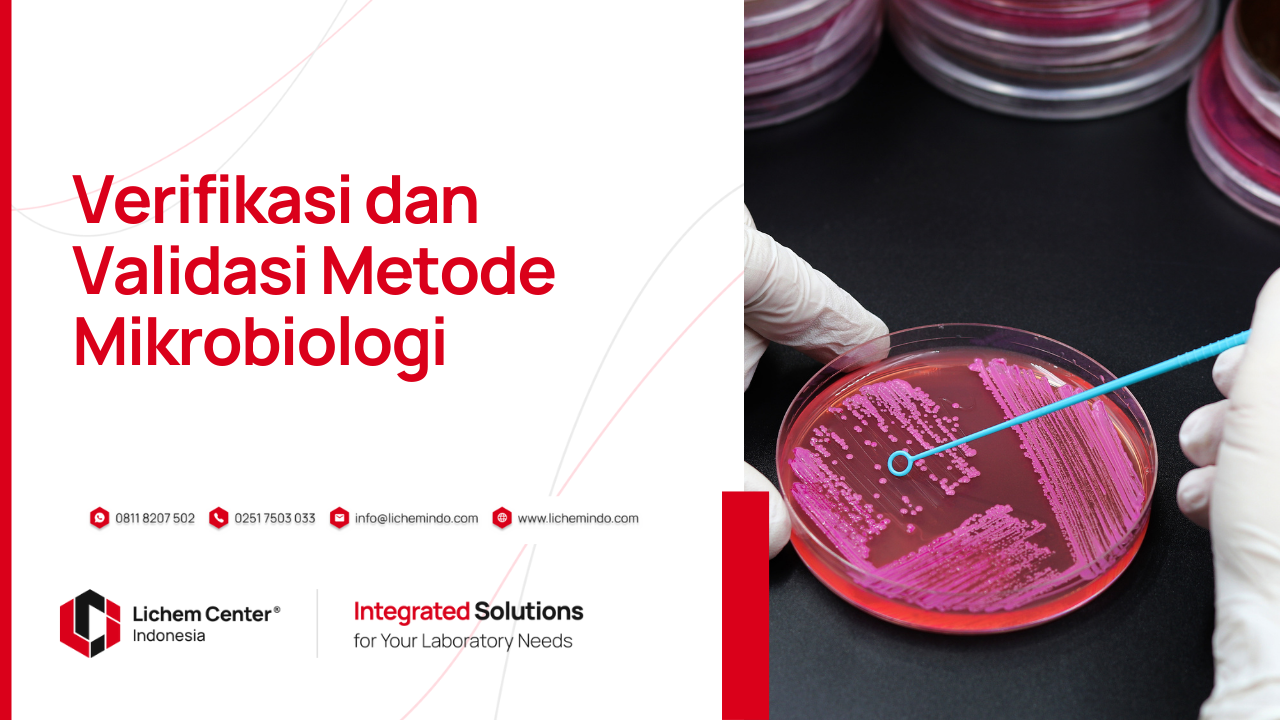
Konsultasi training verifikasi & validasi metode mikrobiologi

Verifikasi dan Validasi Metode Mikrobiologi : Menjamin Keabsahan Hasil Uji Laboratorium

Pendahuluan
Verifikasi dan validasi metode mikrobiologi merupakan dua proses penting yang wajib dilakukan oleh laboratorium untuk menjamin mutu dan keabsahan hasil uji. Terutama dalam pengujian air, parameter mikrobiologi seperti total koliform, Escherichia coli, dan jumlah total bakteri memainkan peran vital dalam menilai keamanan dan kelayakan suatu sumber air.
ISO/IEC 17025:2017 menekankan pentingnya pemastian validitas hasil, dan salah satu caranya adalah dengan menerapkan proses verifikasi dan validasi metode secara sistematis. Dalam artikel ini, kita akan membahas apa yang dimaksud dengan verifikasi dan validasi metode mikrobiologi, kapan proses ini diperlukan, serta bagaimana langkah-langkah pelaksanaannya di laboratorium.
Apa Itu Verifikasi dan Validasi Metode Mikrobiologi?
Validasi metode
Validasi metode adalah proses pembuktian bahwa suatu metode pengujian sesuai untuk tujuan penggunaannya dan mampu menghasilkan data yang akurat, presisi, dan dapat ditelusuri. Validasi diperlukan untuk metode non-standar, in-house method, atau metode standar yang digunakan pada matriks baru.
Verifikasi metode
Verifkasi metode adalah proses konfirmasi bahwa suatu metode yang telah divalidasi dapat diterapkan secara andal dalam kondisi operasional laboratorium tertentu. Verifikasi biasanya dilakukan untuk metode standar yang sudah tervalidasi sebelumnya.
Dengan kata lain, validasi membuktikan metode itu “layak digunakan”, sementara verifikasi membuktikan metode itu “layak digunakan di laboratorium Anda”.
Baca juga mengenai artikel mengenai Verifikasi dan Validasi Metode Uji Kimia : Langkah Penting dalam Memastikan Akurasi Hasil Pengujian
Mengapa Verifikasi dan Validasi Metode Mikrobiologi Penting?
Dalam konteks mikrobiologi air, hasil pengujian sering digunakan untuk kepentingan kesehatan masyarakat, pengawasan industri, hingga audit lingkungan. Kesalahan dalam hasil bisa berdampak serius. Oleh karena itu, verifikasi dan validasi metode mikrobiologi bukan sekadar formalitas akreditasi, melainkan jaminan bahwa laboratorium bekerja dengan metode yang benar, pada kondisi yang sesuai, dan menghasilkan data yang dapat dipertanggungjawabkan.
Standar dan Referensi yang Umum Digunakan dalam Verifikasi dan Validasi Metode Mikrobiologi
Untuk melakukan verifikasi dan validasi metode mikrobiologi, laboratorium dapat merujuk ke dokumen berikut:
-
ISO/IEC 17025:2017 (klausa 7.2 & 7.7)
-
ISO 16140-1:2016 (untuk validasi metode alternatif)
-
ISO 13843:2017 (untuk metode kuantitatif mikrobiologi air)
-
SM APHA 9020 B10/B11 edisi 24 (2023)
-
SAC-SINGLAS Guidance Notes 6/2019
Karakteristik Kinerja yang Harus Diuji
-
Untuk Metode Kualitatif:
-
Sensitivitas: Kemampuan mendeteksi bakteri target (True Positive)
-
Spesifisitas: Kemampuan tidak memberikan hasil positif palsu (True Negative)
-
False Positive Rate dan False Negative Rate
-
Efisiensi: Kombinasi sensitivitas dan spesifisitas
-
Selektivitas: Kemampuan membedakan mikroorganisme target dari flora lain
-
Untuk Metode Kuantitatif:
-
Akurasi: Kedekatan nilai hasil uji dengan nilai sebenarnya
-
Presisi (repeatability & reproducibility)
-
Recovery: Persentase hasil spike yang terdeteksi
-
LoD (Limit of Detection) dan LoQ (Limit of Quantification)
-
Rentang hitung (Counting Range)
-
Robustness: Ketahanan metode terhadap variasi operasional
Langkah-Langkah Verifikasi Metode Mikrobiologi
Verifikasi biasanya dilakukan saat laboratorium mengadopsi metode standar. Berikut langkah yang umum diterapkan:
-
Siapkan spike sample: Air steril yang ditambahkan mikroba target (misal E. coli) sebanyak 10–60 CFU.
-
Lakukan pengujian sesuai metode yang akan diverifikasi (contoh: MPN, membrane filter).
-
Konfirmasi hasil presumptif untuk menghitung:
-
Sensitivitas = a / (a + b)
-
Spesifisitas = d / (c + d)
-
FPR = c / (a + c)
-
FNR = b / (b + d)
-
Keterangan: a = true positive, b = false negative, c = false positive, d = true negative.
Langkah-Langkah Validasi Metode Mikrobiologi
Jika laboratorium mengembangkan metode sendiri atau menggunakan metode standar untuk sampel yang berbeda dari yang direkomendasikan, maka validasi metode wajib dilakukan.
-
Uji presisi: Lakukan pengulangan oleh analis yang berbeda dan alat berbeda.
-
Uji recovery: Spike sampel dengan mikroba target dan bandingkan hasilnya dengan nilai nominal.
-
Tentukan rentang kerja: Berapa jumlah koloni yang masih bisa dihitung akurat (misal 30–300 CFU untuk cawan agar).
-
Robustness: Uji ketahanan metode saat dilakukan variasi suhu, waktu inkubasi, atau pH media.
-
Evaluasi ketidakpastian: Hitung ketidakpastian hasil pengukuran berdasarkan variasi yang muncul selama validasi.
Tips Praktis
-
Selalu dokumentasikan proses verifikasi dan validasi metode mikrobiologi, termasuk protokol, hasil perhitungan, grafik, dan kesimpulan.
-
Gunakan CRM (Certified Reference Material) jika tersedia untuk uji recovery dan akurasi.
-
Diskusikan hasil validasi dengan penanggung jawab teknis atau manajer mutu untuk penilaian akhir sebelum metode digunakan secara rutin.
Kesimpulan
Verifikasi dan validasi metode mikrobiologi adalah langkah fundamental dalam membangun kepercayaan terhadap hasil uji laboratorium. Dengan melakukan kedua proses ini secara benar, laboratorium tidak hanya memenuhi tuntutan ISO/IEC 17025, tetapi juga meningkatkan kualitas, efisiensi, dan kredibilitas operasionalnya. Dengan begitu, laboratorium siap menghadapi tuntutan akreditasi, audit eksternal, maupun ekspektasi pelanggan terhadap hasil uji mikrobiologi yang akurat dan terpercaya.

Baca artikel lainnya
Jaminan Mutu Hasil Uji Laboratorium Berdasarkan ISO/IEC 17025:2017
Tips dan Trik Titrasi : Memastikan Hasil Uji Akurat dan Presisi
7 Kesalahan Dalam Mengoperasikan Instrumen pH meter